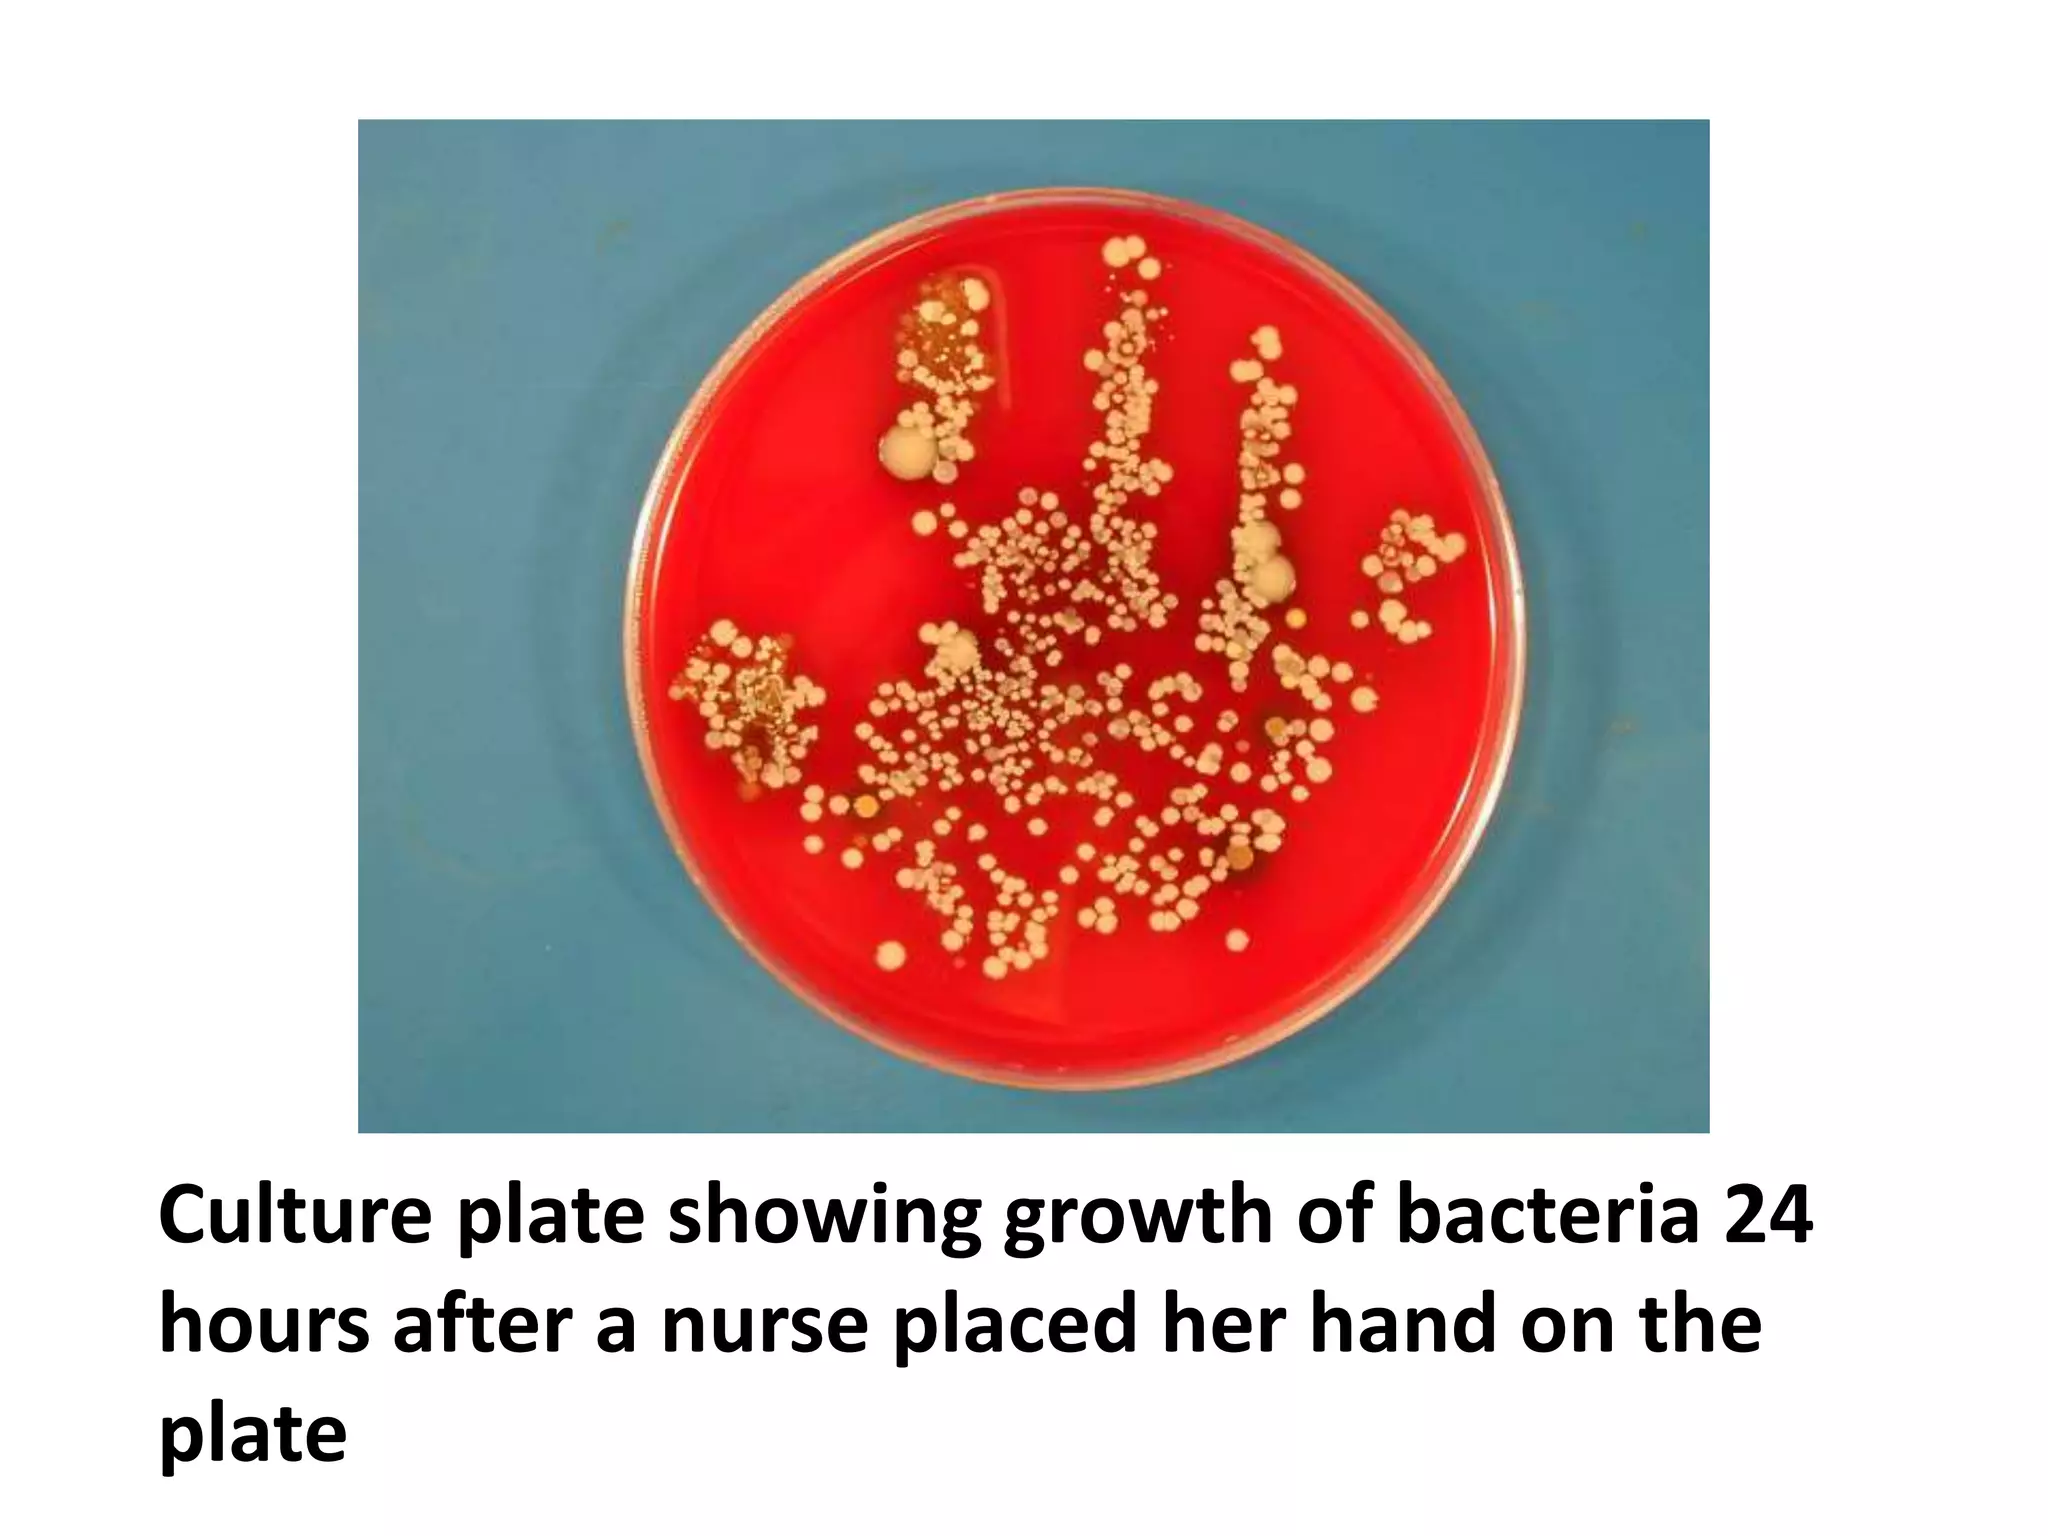
Culture plate showing growth of bacteria 24
hours after a nurse placed her hand on the
plate

Standard precautions are guidelines that all healthcare workers should follow at all times with all patients to reduce the transmission of infections. They include hand hygiene, use of personal protective equipment, cleaning and disinfection of patient care equipment, environmental cleaning, and proper handling of linens and sharps. Additional precautions, including airborne, droplet and contact precautions, may be required for patients known or suspected to have certain infectious diseases to interrupt their transmission. These involve isolation techniques tailored to the pathogen's mode of transmission.

![1. Airborne precautions
• For patients known or suspected to be infected with
pathogens that can be transmitted by the airborne
route
– eg. TB
– Respiratory tract infections,
Airborne transmission occurs
1. Airborne droplet nuclei
– small-particles [<5μm] of evaporated droplets that may
remain suspended in the air for long periods of time
2. Dust particles containing the infectious agent.](https://image.slidesharecdn.com/standardprecaution-221208064455-4d044332/75/Standard-Precaution-ppt-37-2048.jpg)











